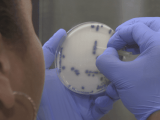
Photo #11114

Le Médipôle et l'Institut Pasteur à l'affût des bactéries résistantes
09 Septembre 2025, 08:15
09 Septembre 2025, 08:15 Les bactéries résistantes aux antibiotiques: un phénomène mondial très inquiétant qui n'épargne pas la Nouvelle-Calédonie. Afin de mieux comprendre ces résistances qui émergent et se propagent, les équipes du CHT et de l'Institut Pasteur mettent en commun leurs recherches.
Commentaires (0)